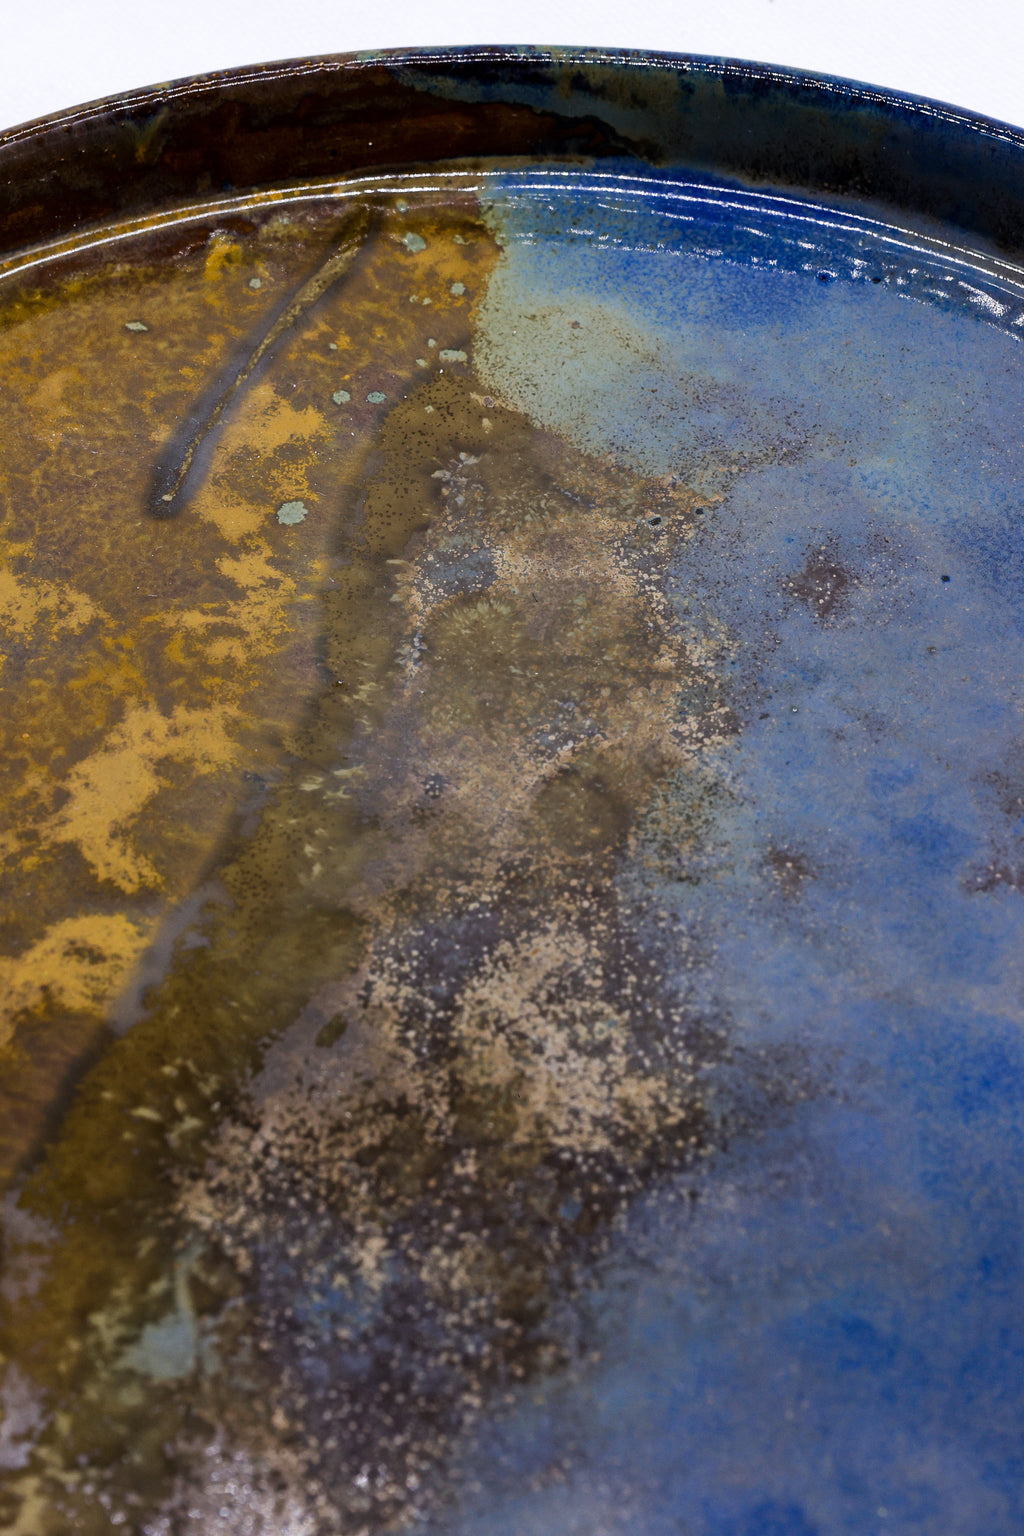
27 cm Oceanis Smoked Grey Large Stoneware Handmade Ceramic Dinner Plate

Pickup currently not available
A Dinner Plate That Actually Looks Rather Good
Right, let's be honest. Most dinner plates are, well, rather forgettable affairs. This one, however, is a properly handsome piece of handcrafted stoneware that sits somewhere between a moody storm cloud and that sophisticated dinner party you've been meaning to host. The smoked grey glaze has a depth and richness that photographs rather marvellously and somehow makes your cooking look substantially better than it actually is.
Why Choose Our Smoked Grey Dinner Plate
Beautifully Crafted by Hand: Each plate is handmade from high quality stoneware clay, which means no two are quite identical. Gloriously imperfect in all the right ways.
That Rather Marvellous Colour: The deep smoked grey finish is utterly fetching. It works with absolutely everything on your table and rather generously doesn't show the crumbs.
Properly Durable: Stoneware that's been made to last, which is rather more than you can say for most things these days. Food safe glaze, dishwasher safe, and splendidly built to withstand the chaos of real life.
A Genuinely Gorgeous Size: At 27cm across, it's substantially generous without being ridiculous about it.
Product Details
Dimensions: 27cm width, 27cm depth, 2cm height. 10.6 inches diameter if you're keeping track.
Material: High quality stoneware clay, handcrafted with considerable care and attention.
Glaze: Food safe, high grade finish in smoked grey.
Maintenance: Dishwasher safe for those of us who prefer modern conveniences.
This is the sort of dinner plate that makes your table feel like you've got your life rather sorted. Rather fetching indeed.
SHIPPING + RETURNS
THE RATHER IMPORTANT BITS
This rather lovely piece ships directly from our brand partner - we work with independent brands who are absolutely brilliant and work frightfully hard to create beautiful things.
SHIPPING DESTINATIONS
Now, here's the thing - our wonderful brand partners ship to lots of different places, but not all of them can ship worldwide.
Some are brilliant at international shipping, others prefer to keep things closer to home.
At checkout, you'll see exactly where this particular brand can send your goodies.
We're terribly sorry, but shipping costs do vary rather wildly depending on where you are in the world. The exact figures pop up at checkout - no nasty surprises!
RETURNS
You have 14 days to return items.
Now, we absolutely adore our brand partners - they work incredibly hard and we do try to support them as much as we possibly can. So I'm rather afraid we have to pass the return postage costs back to you. Frightfully sorry about that!
🌍 PLEASE CHOOSE THOUGHTFULLY:
Our wonderful partners put their hearts into everything they make.
Ordering multiple sizes to try at home is rather hard on our planet and makes things jolly difficult for these brilliant independent creators.
When in doubt, do ask us first!
PAYMENT
We're frightfully modern and accept all the usual suspects:
Visa, Mastercard, American Express, PayPal, Apple Pay, Google Pay, and Shop Pay
SECURE AS HOUSES
Everything's properly encrypted and secure - your details are safer than the Crown Jewels!
All prices in lovely British pounds £ GBP, though international chaps will see converted prices.
Any payment pickle? We're here to help sort things out! Contact us
We Have Lots More Like This.........
Hello, we are Sostter....
Sostter began, as all good ideas do, with a lively conversation and a shared sense of frustration. Why had the world of independent design become so serious, so samey, so… beige? Where was the spark, the imagination, the sheer joy of discovering something that made you stop and stare?
We dreamt of a marketplace that celebrated difference — where curious minds could explore a world of independent brands, design-led makers, and thoughtful artisans. A space that felt exciting, human, and beautifully imperfect. Today, Sostter brings together remarkable people and their creations — from London to Lausanne, Brooklyn to Berlin — uniting makers and discoverers through craftsmanship, creativity, and conscience.
Every object tells a story, and every purchase supports an independent brand doing things differently. Explore our British makers, discover sustainable brands, browse women-led businesses, find the perfect gift for her, or simply wander through our new arrivals and see what finds you.
This is just the beginning. But enough about us — read all about us, or step inside and see what catches your imagination.
A Curated Marketplace for Independent Ethical Brands
Discover our world of independent brands, conscious design, and purposeful creativity — all in one place.
Sostter is more than a marketplace. We're here to inspire a more thoughtful way to shop — one that celebrates the makers, the dreamers, and the independent brands doing things properly. Every brand on Sostter has been individually vetted for its originality, quality, and values. From sustainable fashion and ethical homeware to handmade jewellery and design-led gifts — all brought together in one considered space. Browse by location, by purpose, or simply wander and see what finds you. Want to sell with us? We'd love to hear from you.
Be the first to know
Sign up to our emails for brand new small business magic and inspiration, and lots of lovely discounts and Sostter news